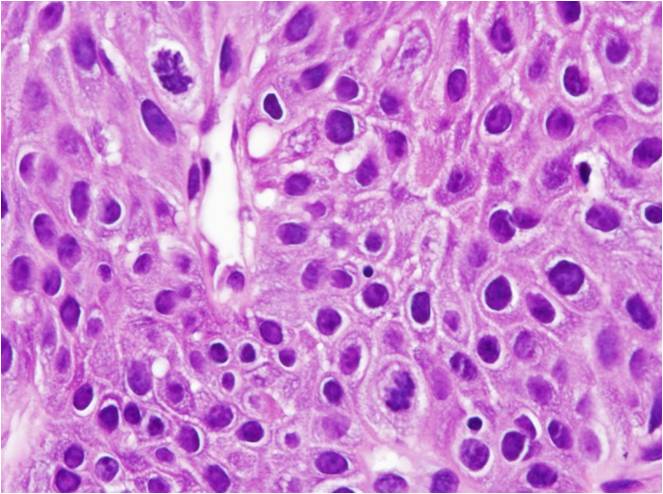

又称为多灶性上皮增生、赫克病(Heck’s disease)等,是一种罕见的病毒诱导的局限性鳞状上皮增殖,目前已明确该病是与HPV亚型13和32密切相关。多发于儿童,无明显性别差异,最常见受累部位包括唇、颊、舌和牙龈黏膜。 临床表现为多发、质软、扁平的丘疹,常聚集成簇,颜色常与正常黏膜相同。病变小(1-10mm),常无症状,多为偶然发现。

显微镜下见鳞状上皮增生伴棘层增厚和表层不全角化,增厚的上皮向上延伸而不向下延伸到固有层,上皮钉突变宽,常汇合在一起,有时呈球棒状。表浅棘层细胞常见凹空细胞样改变。有时可见表层细胞细胞核呈有丝分裂样改变,称为有丝分裂样细胞。固有层常较疏松,血管丰富,有不同程度淋巴细胞浸润。
高倍镜显示有丝核分裂样细胞
